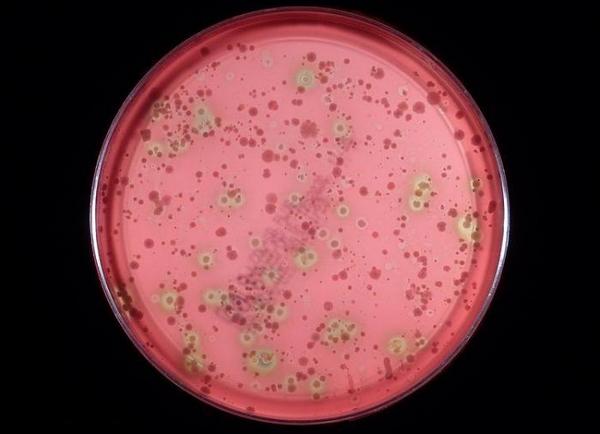
стрептококк вириданс

В микрофлоре человека бурлит своя лишь ей присущая жизнь. Научным работникам понадобились длительные годы, чтобы определить, насколько много самых различных бактерий живет во рту у человека, его глотке, желудочно-кишечном тракте, половых и всех остальных органах. Многие из них приносят невероятную помощь в работе той или иной системы, оставаясь при этом практически не замеченными.
Есть среди них и те, которые до определенного момента живут и не причиняют вреда человеку. Но может случиться сбой в организме и та бактерия, которая еще вчера была безвредной становится очень опасной. Именно такими бактериями и являются стрептококки, в частности стрептококк вириданс.
Они не всегда опасны для людей. Но так длится лишь до тех пор, пока они находятся в нормальных условиях. Стоит только случиться внутри организма какому-нибудь колебанию на фоне болезни или пониженного иммунитета, стрептококки сразу же дают о себе знать.
Что такое стрептококки?
Данные микроорганизмы —, это отдельный род бактерий, живущих внутри людей и животных. Группа стрептококков представляет собой довольно обширную зону. Эти условно-патогенные микроорганизмы нередко находят пристанище в человеческом теле. Большая часть их видов так и остается незамеченной на протяжении всей жизни человека. Чего нельзя сказать о стрептококке вириданс или зеленящем, который является неотъемлемой частью нормальной микрофлоры в полости рта, глотке, ЖКТ, в органах дыхания. Таких микроорганизмов огромное количество в природе. Они до определенного момента не причиняют людям вреда. Но стоит произойти сбою в иммунной системе человека, как присутствие бактерий становится невероятно опасным.
Врачи отмечают, что стрептококк вириданс, являясь частью нормальной микрофлоры ротовой полости, может стать причиной различных инфекционных заболеваний. Эти бактерии, хотя и считаются условно патогенными, могут вызывать серьезные осложнения, особенно у пациентов с ослабленным иммунитетом или имеющих хронические заболевания. Врачи подчеркивают важность регулярной гигиены полости рта и профилактических осмотров, чтобы минимизировать риск инфекций. Также они рекомендуют обращать внимание на любые симптомы, такие как боль в горле или воспаление десен, так как это может указывать на активизацию стрептококков. Важно помнить, что своевременное обращение к специалисту может предотвратить развитие более серьезных заболеваний, связанных с этой бактерией.
https://youtube.com/watch?v=aKQs-7QUMeU
Streptococcus viridans
Простейшие микроорганизмы, локализующиеся в полости рта, ЖКТ, в системе органов дыхания и мочеполовой системе и составляют около 30–60% из всех бактерий, находящихся в людях. Проникают они в организм вместе с пищевыми продуктами.

С помощью светового микроскопа можно рассмотреть, как они выглядят. Данные бактерии представляют собой неподвижную цепочку, состоящую из шариков. Соприкосновение их с клетками крови изменяет цвет бактерий, поэтому их еще называют зелеными.
Самыми частыми отрицательными последствиями деятельности этих бактерий являются следующие заболевания:
При проникновении стрептококков в кровеносные сосуды, сердце, мозг и мочеполовую систему могут возникнуть необратимые осложнения.
Существует много путей попадания стрептококков в кровеносную систему:
Симптомы

Существуют определенные признаки, с помощью которых можно заподозрить то, что стрептококки вириданс вышли из состояния спокойствия:
Стрептококк Вириданс — это группа бактерий, которые часто встречаются в ротовой полости и являются частью нормальной микрофлоры человека. Многие люди не подозревают о их существовании, пока не столкнутся с проблемами, связанными с зубами или деснами. Врачи отмечают, что эти микроорганизмы могут вызывать инфекции, особенно у людей с ослабленным иммунитетом или при наличии хронических заболеваний. Однако, несмотря на потенциальные риски, Стрептококк Вириданс также играет важную роль в поддержании здоровья полости рта, участвуя в процессах ферментации и защиты от патогенных микроорганизмов. Некоторые пациенты выражают беспокойство по поводу их присутствия, но большинство специалистов подчеркивают, что при соблюдении гигиенических норм и регулярных визитах к стоматологу, риск возникновения проблем минимален. Важно помнить, что баланс микрофлоры — ключ к здоровью.
https://youtube.com/watch?v=xNciNNLCpcc
Диагностика
Диагностировать стрептококк вириданс возможно только в лабораторных условиях. В наше время делается это с помощью экспресс-тестов на протяжении нескольких минут. Помимо этого, есть определенные нормы, обязывающие проходить стандартные обследования. На них уходит немного больше времени, но верность результата впечатляет.

Во время стандартной диагностики проводятся все виды обследования, которые способствуют выявлению других болезнетворных микроорганизмов:
Важно знать, что данная бактерия может находиться в любом месте, поэтому, чтобы определить ее местонахождение иногда нужно прибегнуть к сдаче нескольких анализов.
Лечение

Избавиться от данной проблемы можно с помощью антибиотиков пенициллинового ряда и иммуномодуляторов.
Во время лечения детей и женщин используются лекарства более мягкого воздействия. К лечению каждого пациента необходим индивидуальный подход.
В случае аллергических проявлений на медикаменты пенициллинового ряда они заменяются сульфаниламидами.
Токсические вещества выводятся при помощи Атоксила. Есть возможность предупредить рецидив с помощью иммунотерапии.
Народные методы борьбы с стрептококком
Лечиться при помощи народных методов можно, но при этом не стоит исключать медикаментозную терапию. Только так можно достичь положительных результатов.
Существуют определенные продукты питания, которые оказывают антисептические действия. В первую очередь – это продукты пчеловодства – мед, прополис, пчелиная пыльца. Наравне с ними с микробами борются лук и чеснок.

Заболевания горла на фоне стрептококковой инфекции, кроме антибактериальной терапии, желательно сопровождать полосканием горла отваром ромашки, череды или календулы.
Для полного выздоровления организму необходимо достаточное количество витаминов и полезных микроэлементов. Все эти ценные вещества находятся в овощах и фруктах.
Осложнения

Отсутствие необходимого лечения стрептококков приводит к развитию в организме гнойных процессов, что чревато возникновению буквально в считанные дни таких осложнений, как:
В целях профилактики данного заболевания достаточно соблюдать правила личной гигиены и укреплять иммунную систему. При своевременном лечении многих возможных негативных осложнений удается избежать.
https://youtube.com/watch?v=a6edcyahZyA
Вопрос-ответ
Что такое стрептококк Вириданс и где он обычно встречается?
Стрептококк Вириданс — это группа бактерий, которые являются частью нормальной микрофлоры ротовой полости, горла и кишечника человека. Эти микроорганизмы обычно не вызывают заболеваний, но могут стать патогенными при определенных условиях, например, при ослаблении иммунной системы или наличии повреждений тканей.
Как стрептококк Вириданс может влиять на здоровье человека?
Хотя стрептококк Вириданс обычно безвреден, он может вызывать инфекции, такие как эндокардит, особенно у людей с предрасположенностью, например, с пороками сердца. Инфекции могут возникать после стоматологических процедур или при наличии открытых ран, что позволяет бактериям попасть в кровоток.
Как можно предотвратить инфекции, вызванные стрептококком Вириданс?
Для предотвращения инфекций, связанных со стрептококком Вириданс, важно соблюдать хорошую гигиену полости рта, регулярно посещать стоматолога и следить за состоянием здоровья. Людям с высоким риском инфекций, например, с сердечно-сосудистыми заболеваниями, может быть рекомендовано принимать антибиотики перед стоматологическими процедурами.
Советы
СОВЕТ №1
Регулярно проходите медицинские обследования, особенно если у вас есть предрасположенность к инфекциям. Это поможет выявить возможные проблемы на ранней стадии и предотвратить осложнения, связанные со стрептококком Вириданс.
СОВЕТ №2
Обратите внимание на гигиену полости рта. Регулярная чистка зубов и использование антисептических ополаскивателей могут снизить риск заражения стрептококком Вириданс, который часто обитает в ротовой полости.
СОВЕТ №3
Если у вас есть хронические заболевания или ослабленная иммунная система, обсудите с врачом необходимость профилактического лечения или дополнительных мер предосторожности для снижения риска инфекций, связанных со стрептококком Вириданс.
СОВЕТ №4
Следите за симптомами, такими как боль в горле, лихорадка или необычные изменения в состоянии здоровья. При появлении этих признаков не откладывайте визит к врачу для диагностики и лечения.

